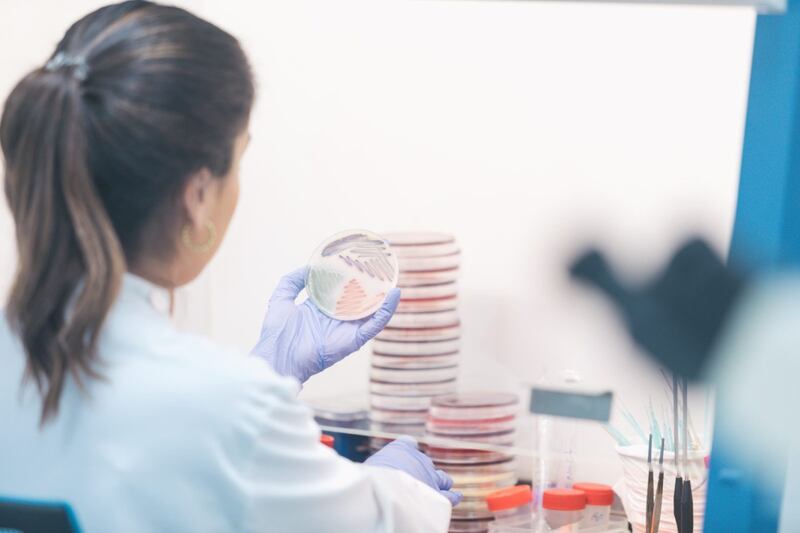
Bióloga

La vida entre perros, gatos y sus dueños no solo es la de compartir momentos agradables. Hay enfermedades que, incluso, podrían transmitirse entre ellos, con bacterias resistentes a los antibióticos como causantes.
Un estudio presentado en Portugal realiza esa sugerencia. Lo realizaron las doctoras Julia Menezes (Universidad de Lisboa) y Sian Frosini (Royal Veterinary College, del Reino Unido). Se hace público en el Congreso Europeo de Microbiología Clínica y Enfermedades Infecciosas, que comenzó este domingo y culmina el miércoles.
Las investigadoras buscaban averiguar cómo se propagan las denominadas “superbacterias”, específicamente las Escherichia coli, Enterobacteriaceae productoras de BLEE y AmpC, y Enterobacterales productoras de carbapenemasas (CPE).
Estas son bacterias resistentes a múltiples antibióticos, incluyendo la penicilina y las cefalosporinas.
Para ello, se recolectaron muestras de heces de 58 personas sanas y los 18 gatos y 40 perros que vivían con ellos en 41 hogares de Portugal, y de 56 personas sanas y 45 perros de 42 hogares en el Reino Unido.
Las muestras se recogieron entre 2018 y 2020 a intervalos mensuales por cuatro meses, utilizándose secuenciación genética para identificar tanto las especies de bacterias en cada muestra como la presencia de genes de resistencia a los medicamentos.
Las conclusiones del estudio sobre bacterias resistentes a antibióticos en perros, gatos y dueños
Los resultados, de acuerdo con el portal ENOVAT, indican que:
- El 15% de los animales y el 13% de los dueños evaluados tenía bacterias productoras de ESBL / AmpC.
- De estos, casi la mitad de los perros y gatos, y un tercio de los miembros del hogar, estaban colonizados con al menos una cepa multirresistente.
- No se detectaron Enterobacterales o Acinetobacter spp resistentes a carbapenem en ninguna de las muestras.

“Nuestros hallazgos verifican no solo el intercambio de bacterias resistentes a los antibióticos, sino también de genes de resistencia entre los animales de compañía y sus dueños en la comunidad”, apunta la doctora Menezes. “Lo que subraya la necesidad de programas de vigilancia locales continuos para identificar el riesgo potencial para la salud humana”.
El estudio no puede probar que el contacto cercano con mascotas provoque la colonización con bacterias resistentes a los antibióticos, pero sí sugiere la posibilidad. Se espera realizar mayores investigaciones al respecto.
